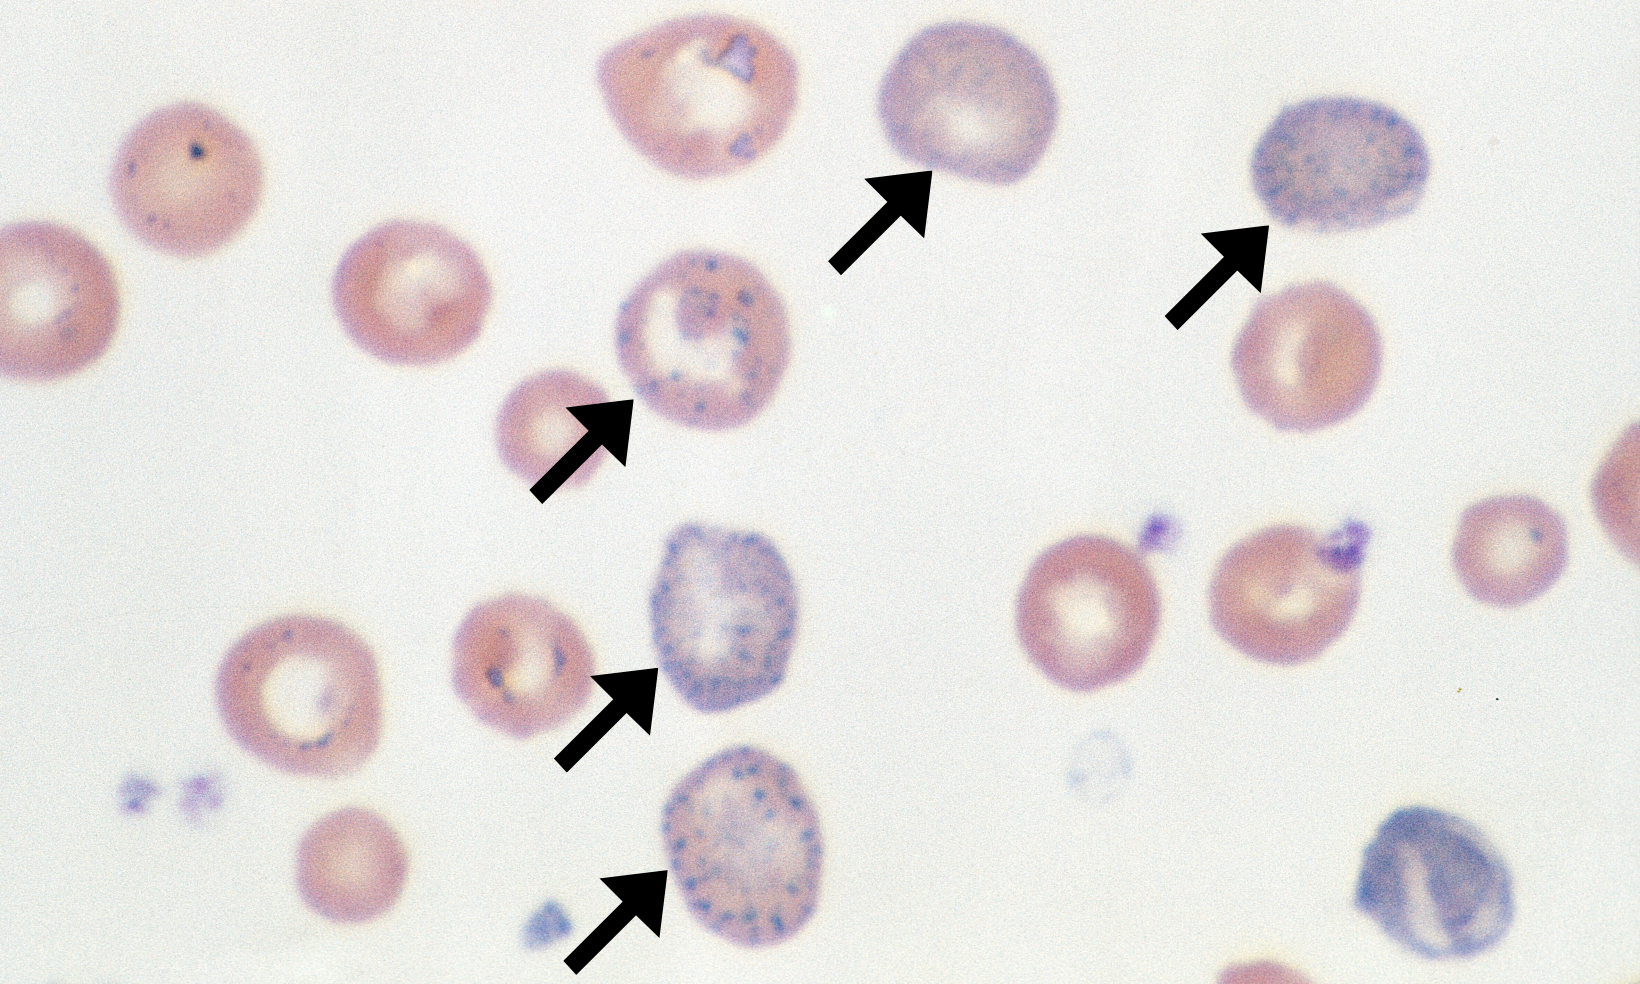
Basophilic Stippling 4 (Bovine 4 - Regen Anemia) ARROWS
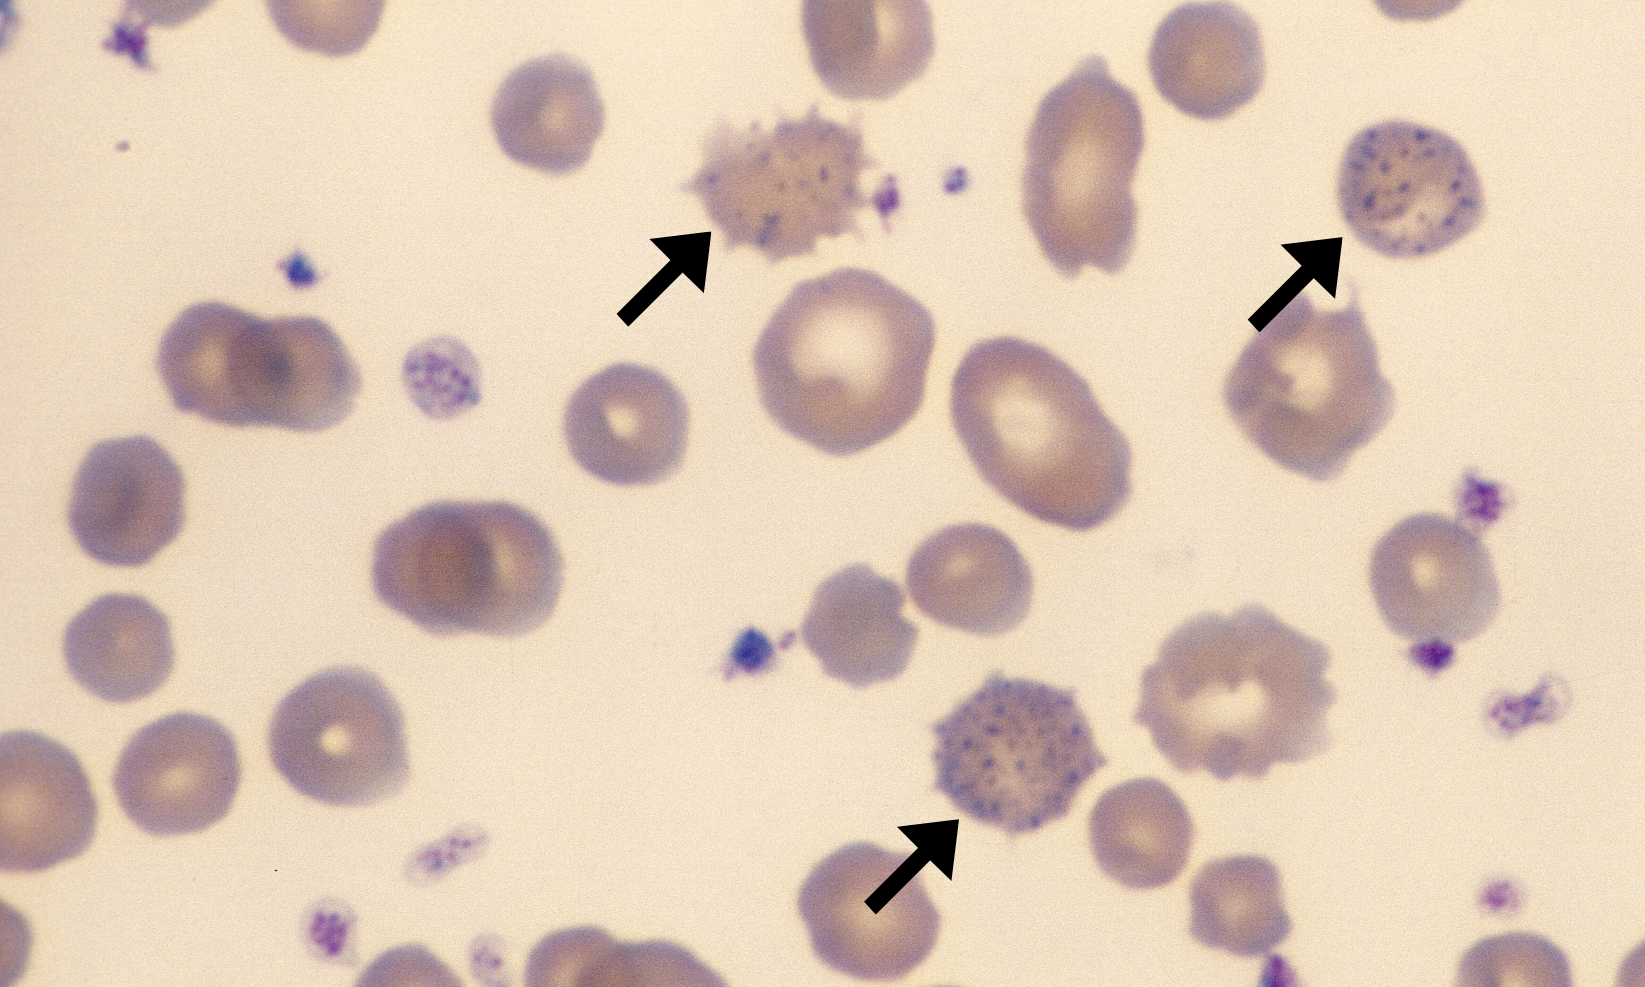
Basophilic Stippling 2 (Bovine 2) ARROWS
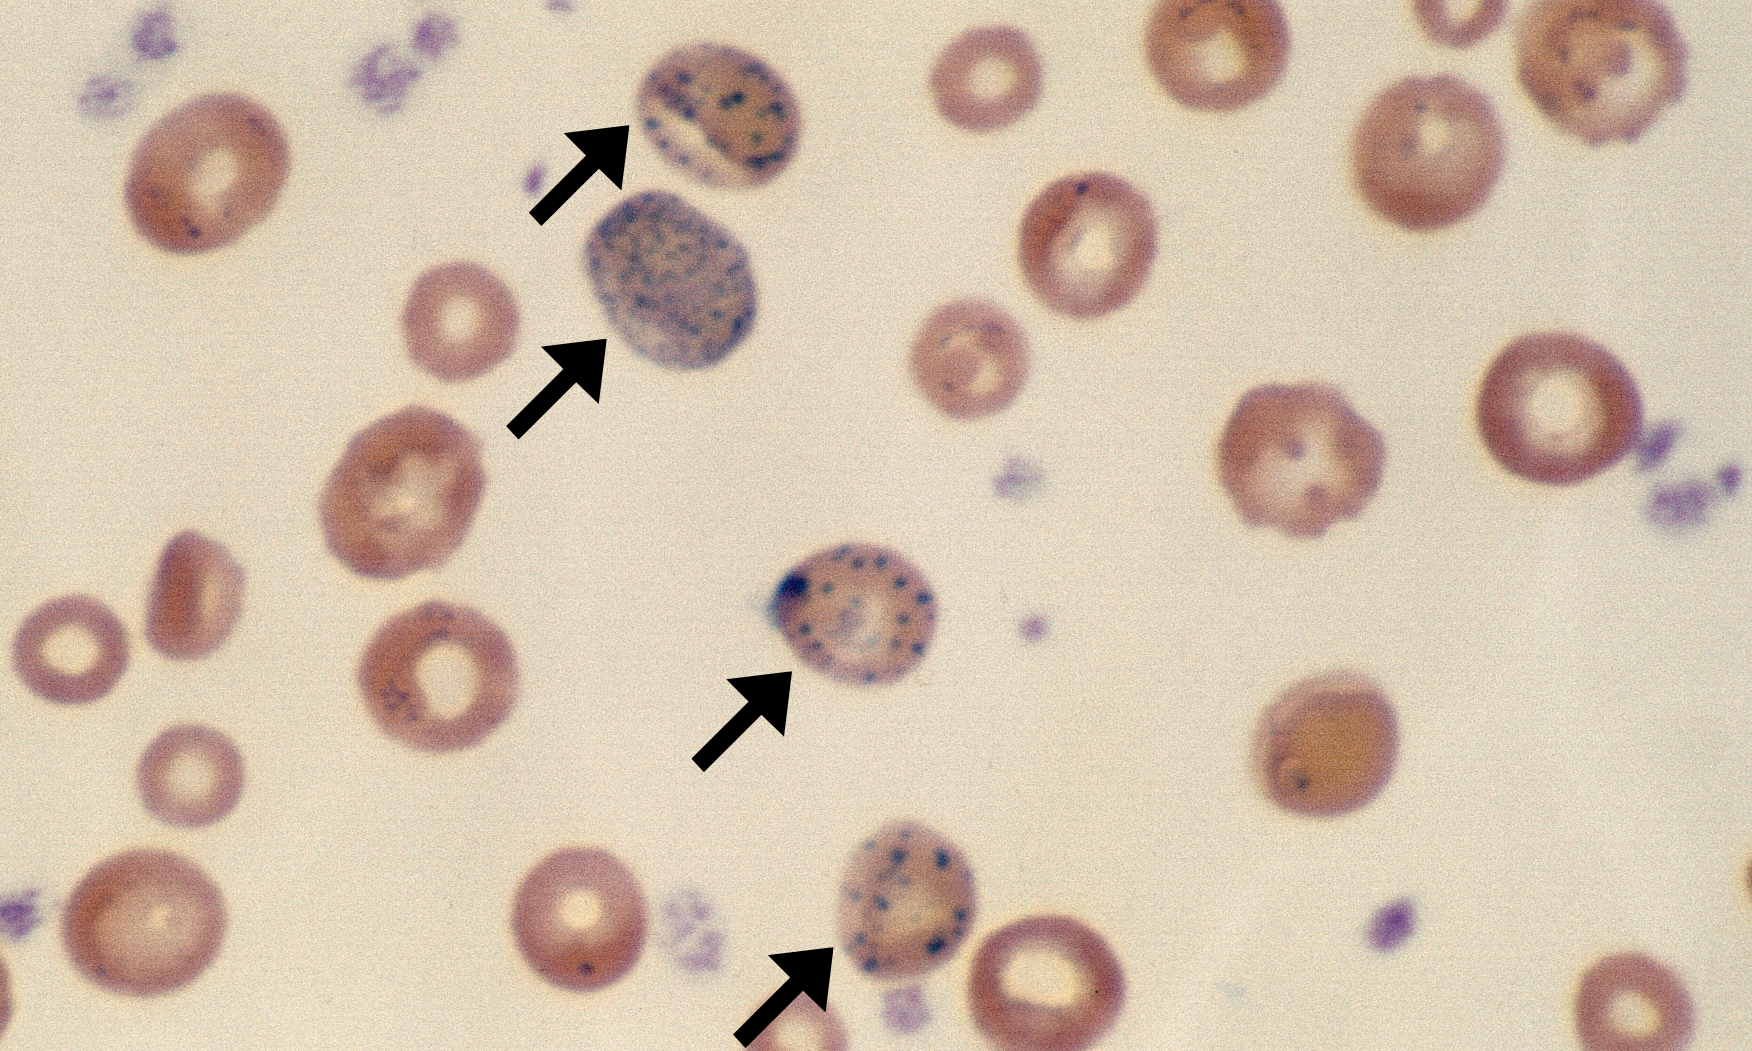
Basophilic Stippling 1 (Bovine 1) ARROWS

Basophilic Stippling
Morphology: numerous small, blue, punctate inclusions in red blood cells. Caused by spontaneous aggregation of ribosomes in the cytoplasm.
Look alike: Mycoplasma
Commonly seen with: features of regenerative anemia (macrocytes, anisocytosis, polychromatophils), features of lead poisoning (nucleated red blood cells, polychromatophils)
Clinical relevance: may be seen with regenerative anemia (especially in cattle but also in dogs and cats). May be seen with lead poisoning in the absence of anemia.